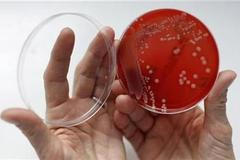
bakterie MRSA

Výpravčí na koridoru: Ahoj Franto! Posílám pendolino
Bezpečnost tisíců cestujících v rukou jediného člověka



Bezpečnost tisíců cestujících v rukou jediného člověka



Protest proběhl v mezích zákona i slušnosti
Hostem Aktuálně.cz byl exposlanec US-DEU



Změní se rovněž okolí Masarykova nádraží



Má poradit řidičům, kde mají jet opatrně



Rozjezd nové digitální stanice přijde na miliardu
Kraj zaplatí očkování žákům 1. tříd



Jeho plán je jen pracovní, ale kontroverzní



Klid ve městě bude hlídat na 800 policistů
Demonstrace proběhnou v Praze, Vídni a Ottawě

Spor o peníze pro českou vědu vrcholí



Automobilka stále nemá napojení na železnici



28. října budou defilovat i policisté a hasiči



Nejvíce přibývá skleníkových plynů a prachu



Stát poprvé uznal, že v ghettech žijí různí lidé



Teploty jsou extrémně nízké, o víkendu se oteplí



Julínek podle nich experimentuje na pacientech



Muži způsobili škodu přes 34 milionů



Dohodu stvrdil Bursík se svým bavorským kolegou



Do konce listopadu jich přibude dvacet